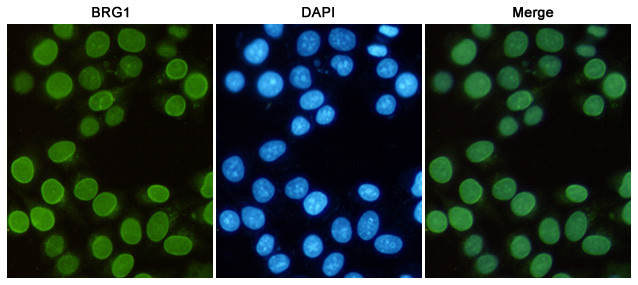
BRG1 Antibody in Immunocytochemistry (ICC/IF)

Search
Invitrogen
BRG1 Monoclonal Antibody (6D7)
{{$productOrderCtrl.translations['antibody.pdp.commerceCard.promotion.promotions']}}
{{$productOrderCtrl.translations['antibody.pdp.commerceCard.promotion.viewpromo']}}
{{$productOrderCtrl.translations['antibody.pdp.commerceCard.promotion.promocode']}}: {{promo.promoCode}} {{promo.promoTitle}} {{promo.promoDescription}}. {{$productOrderCtrl.translations['antibody.pdp.commerceCard.promotion.learnmore']}}





Please note: We are reviewing Western blot images included in the antibody testing data in our catalog, including those provided by third parties. Unless expressly labeled or annotated as “raw-unedited”, Western blot images included in the antibody testing data in our catalog may have been edited, optimized or otherwise adjusted for presentation.
产品信息
MA5-32973
种属反应
宿主/亚型
分类
类型
克隆号
抗原
偶联物
形式
浓度
规格
纯化类型
保存液
内含物
保存条件
运输条件
RRID
产品详细信息
Purity is > 95% by SDS-PAGE.
靶标信息
Brg1 (Brahma-related gene 1) is an ATPase subunit of SWI2/SNF2-like chromatin-remodeling complexes that enable access of regulatory and effector proteins in transcription, DNA repair and DNA replication. Although Brg1-containing complexes are not essential for general cell survival, they participate in transcriptional regulation of several hundred genes including those involved in interferon and stress response, immune cells differentiation, neurogenesis, cell cycle etc. and is absolutely necessary for mouse embryogenesis. Brg1 is also involved in cell growth arrest, senescence and tumour supression.
仅用于科研。不用于诊断过程。未经明确授权不得转售。
篇参考文献 (0)
生物信息学
蛋白别名: ATP-dependent helicase SMARCA4; BAF190A; BRG1-associated factor 190A; FLJ39786; Mitotic growth and transcription activator; Protein brahma homolog 1; Protein BRG-1; SMARCA4; SNF2-beta; SWI/SNF-related matrix-associated actin-dependent regulator of chromatin subfamily A member 4; Transcription activator BRG1
基因别名: b2b508.1Clo; b2b692Clo; BAF190A; BRG1; HP1-BP72; SMARCA4; SNF2B; SNF2beta; SNF2L4; SW1/SNF
UniProt ID: (Mouse) Q3TKT4
Entrez Gene ID: (Mouse) 20586